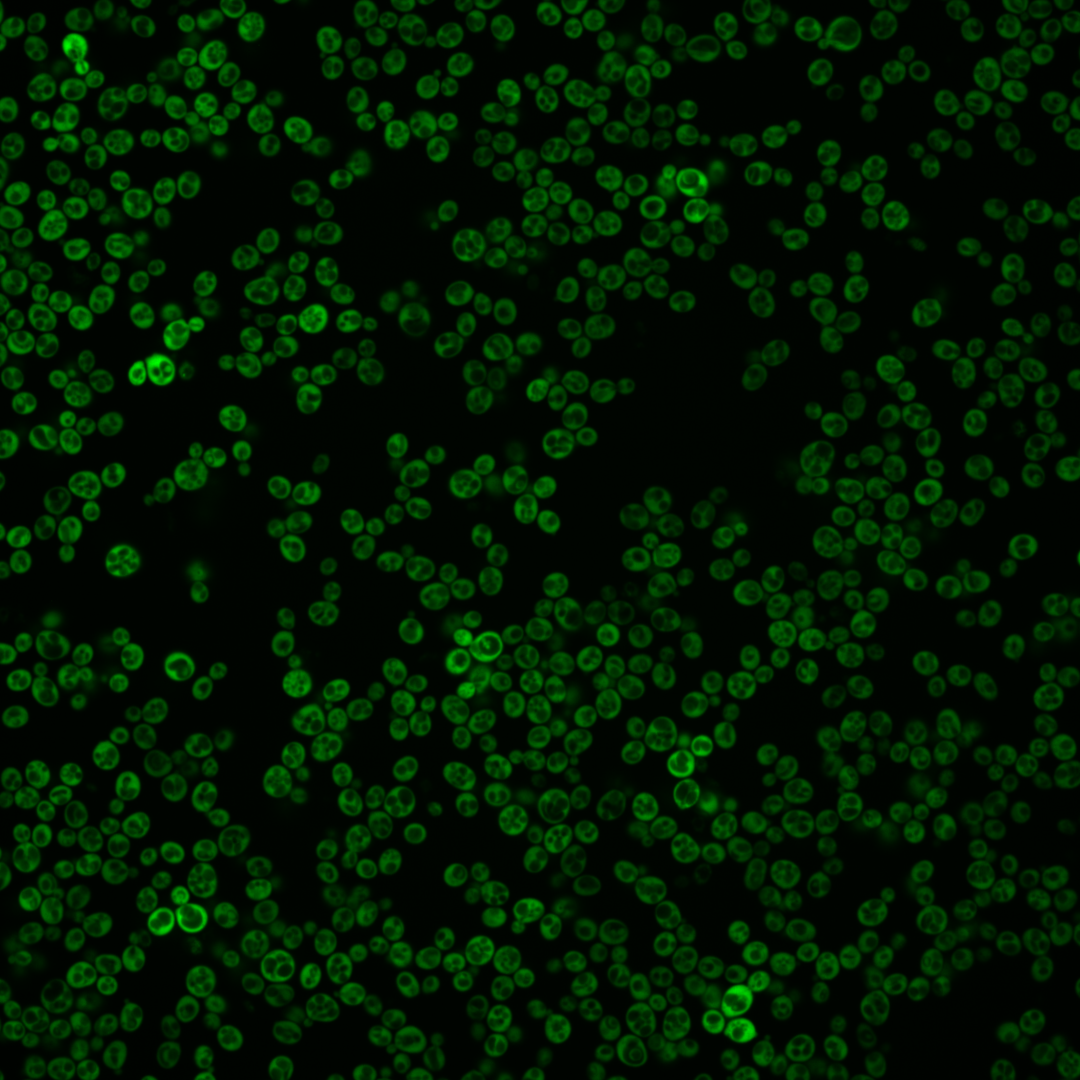
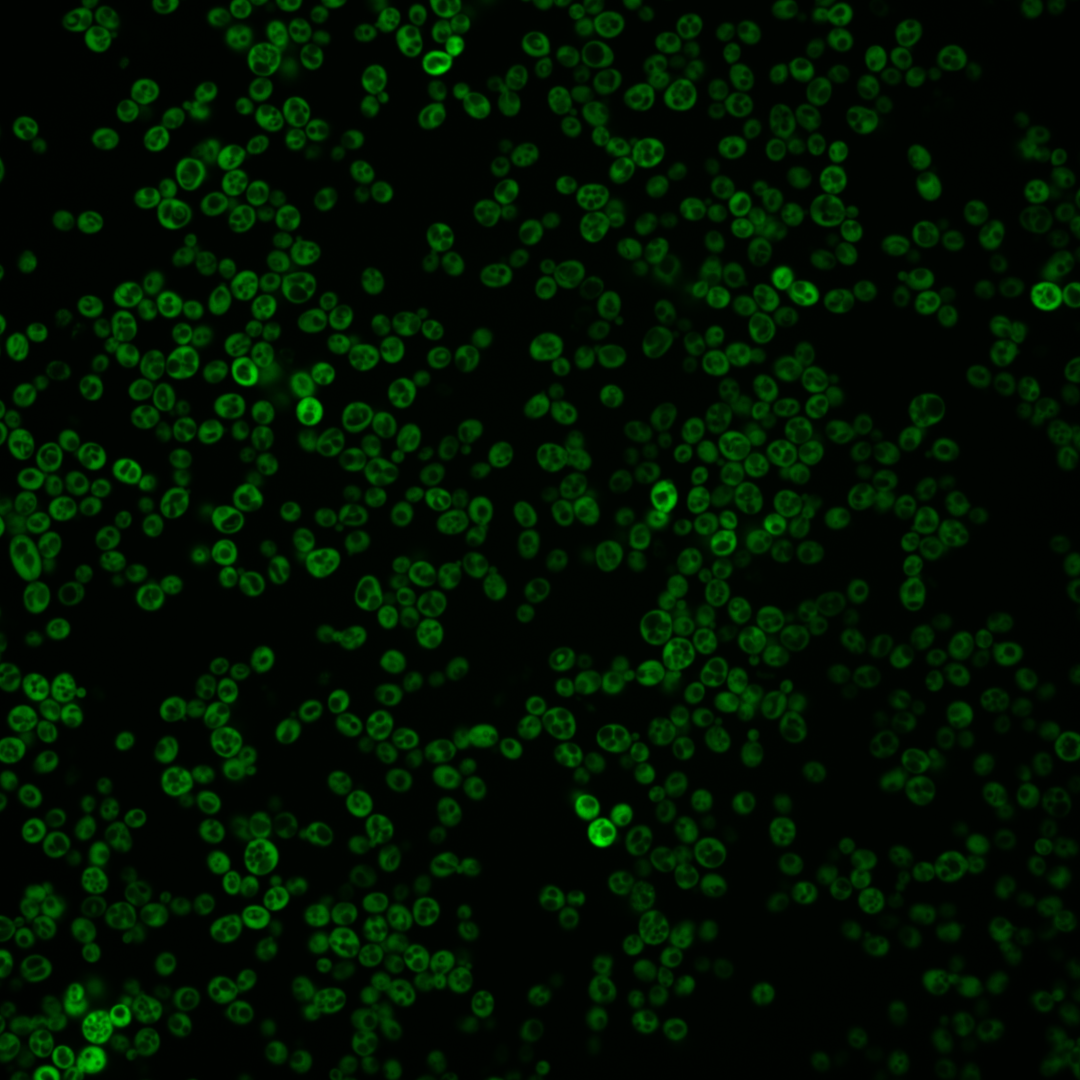
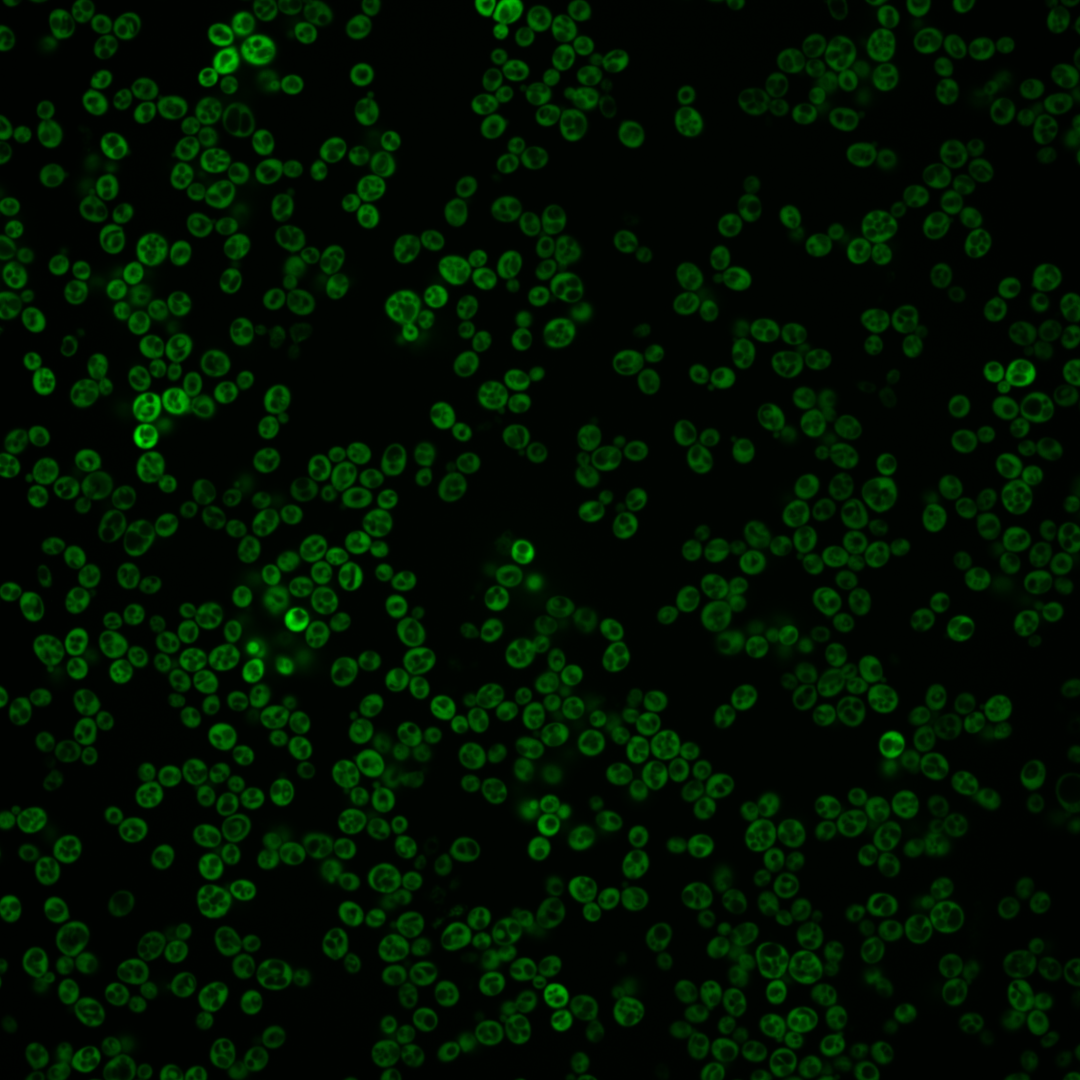
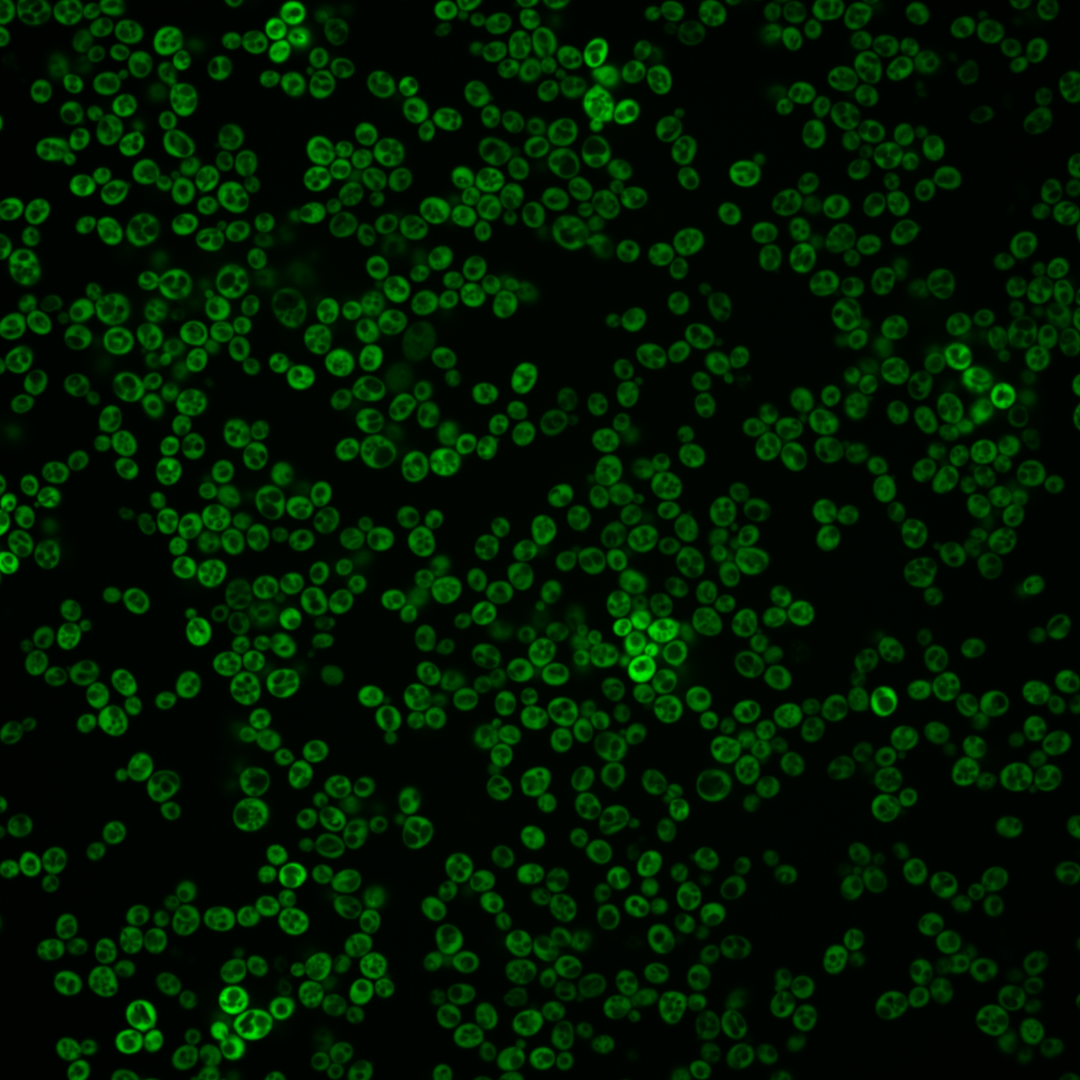
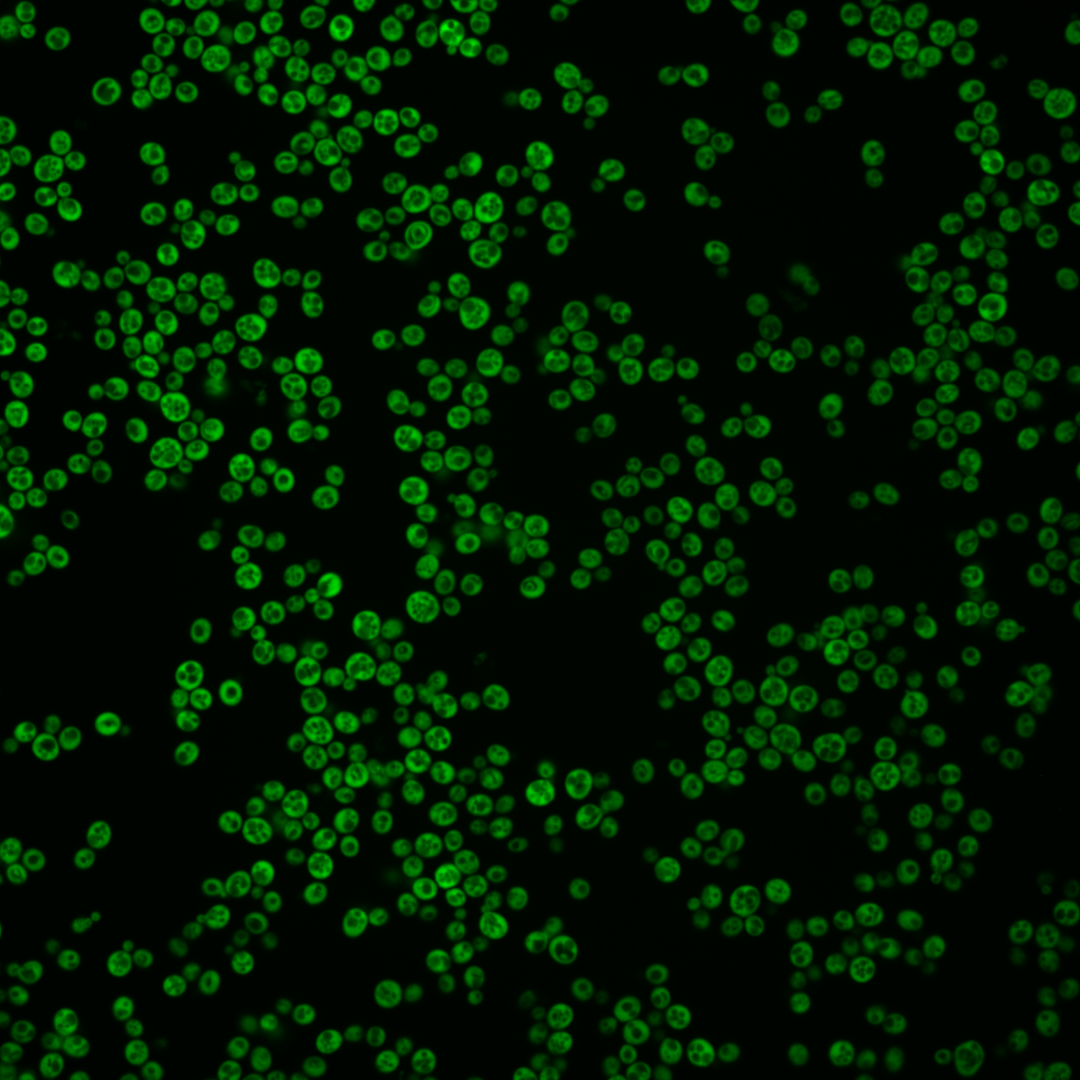
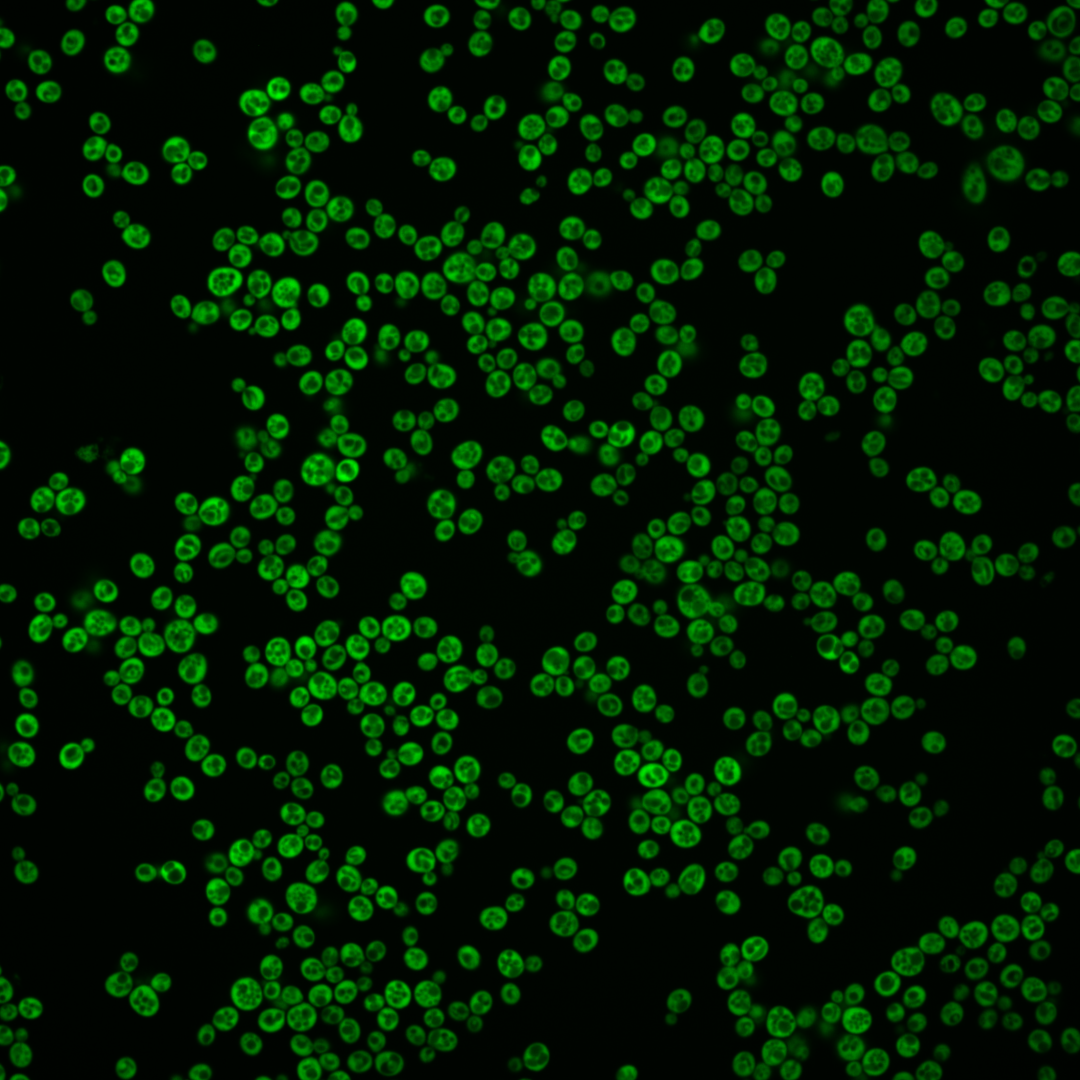
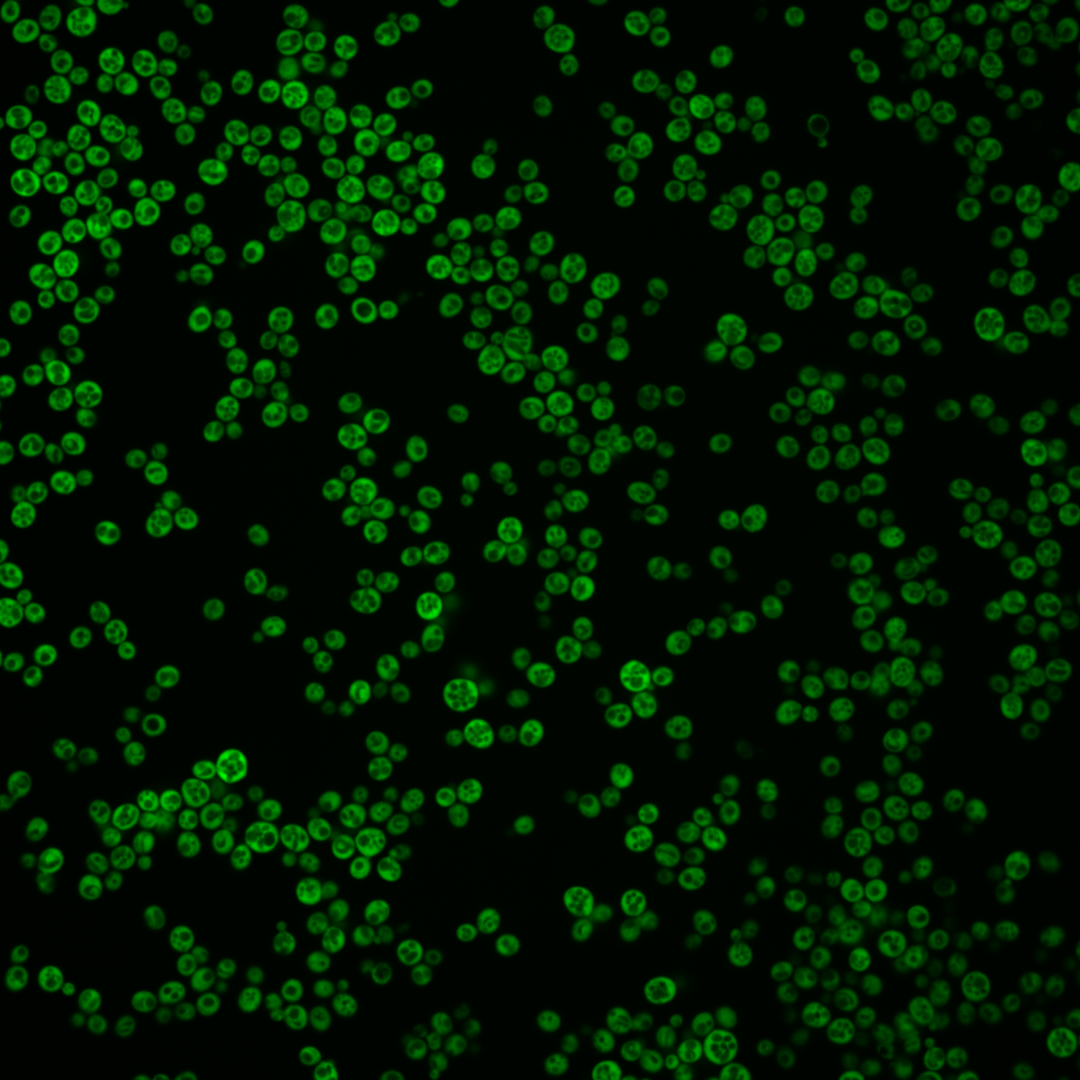
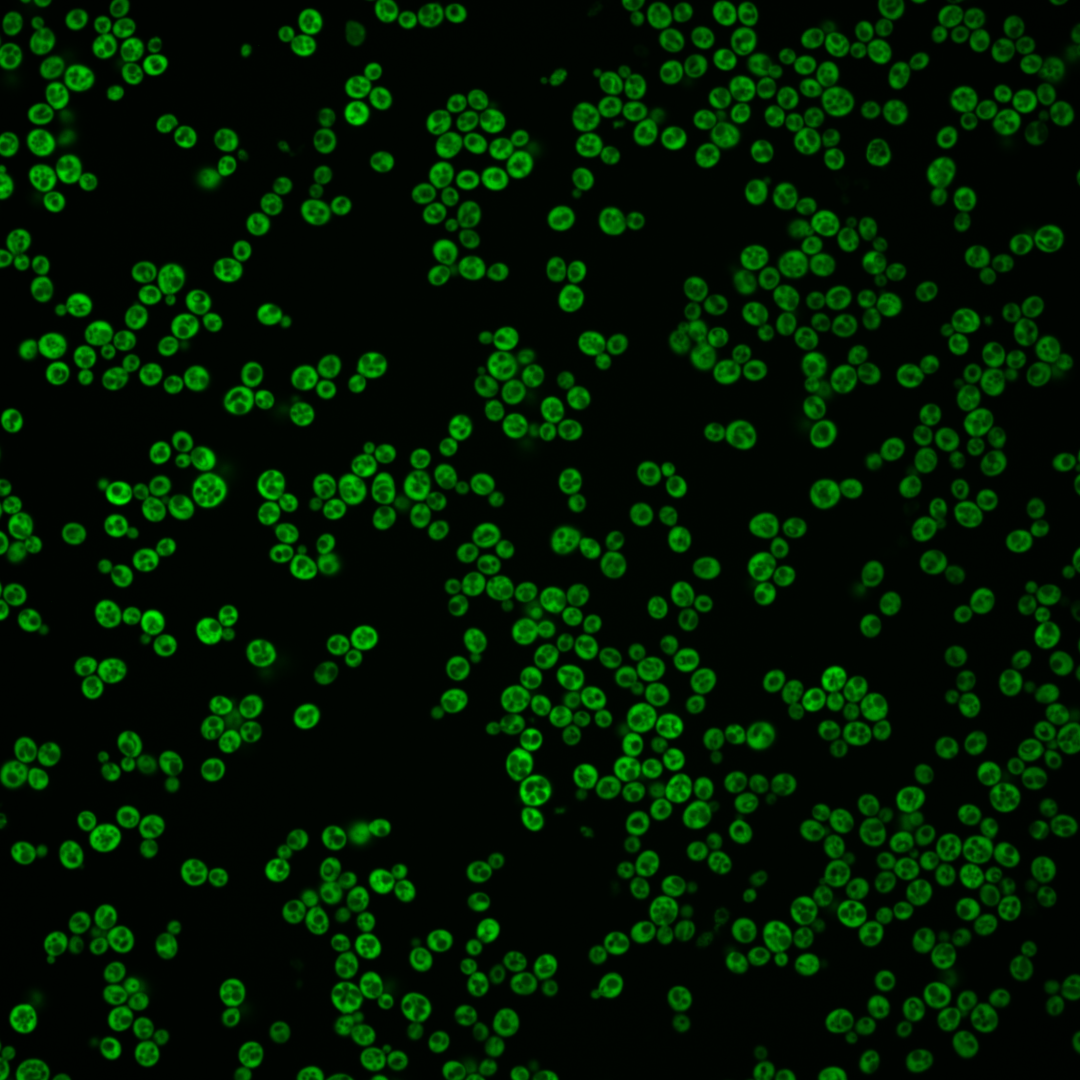

| Standard name | |
|---|---|
| Human Ortholog | |
| Description | Aspartate kinase (L-aspartate 4-P-transferase); cytoplasmic enzyme that catalyzes the first step in the common pathway for methionine and threonine biosynthesis; expression regulated by Gcn4p and the general control of amino acid synthesis |
Micrographs




















































































Sub-cellular Localization
Yeast GFP Assignment
Protein Abundance
Localization Change
External localization resources
| ensLOC | DeepLoc | |||||||||||||||||||||||
|---|---|---|---|---|---|---|---|---|---|---|---|---|---|---|---|---|---|---|---|---|---|---|---|---|
| Localization | WT1 | WT2 | WT3 | RAP60 | RAP140 | RAP220 | RAP300 | RAP380 | RAP460 | RAP540 | RAP620 | RAP700 | HU80 | HU120 | HU160 | rpd3Δ_1 | rpd3Δ_2 | rpd3Δ_3 | WT1 | WT2 | WT3 | AF100 | AF140 | AF180 |
| Cortical Patches | 0 | 0 | 0 | 0 | 0 | 1 | 8 | 7 | 12 | 16 | 4 | 12 | 0 | 0 | 0 | 0 | 0 | 0 | 0 | 0 | 0 | 0 | 0 | 0 |
| Bud | 0 | 0 | 0 | 0 | 0 | 0 | 3 | 2 | 2 | 0 | 0 | 2 | 0 | 1 | 0 | 1 | 0 | 0 | 0 | 2 | 0 | 0 | 1 | 0 |
| Bud Neck | 0 | 0 | 0 | 0 | 0 | 0 | 0 | 0 | 0 | 0 | 0 | 0 | 0 | 0 | 0 | 0 | 0 | 0 | 0 | 0 | 0 | 0 | 0 | 0 |
| Bud Site | 0 | 0 | 0 | 0 | 0 | 0 | 0 | 0 | 0 | 0 | 0 | 0 | 0 | 0 | 0 | 0 | 0 | 0 | – | – | – | – | – | – |
| Cell Periphery | 0 | 0 | 2 | 2 | 5 | 5 | 20 | 10 | 12 | 19 | 5 | 6 | 0 | 0 | 2 | 3 | 6 | 3 | 0 | 0 | 0 | 0 | 0 | 0 |
| Cytoplasm | 128 | 193 | 299 | 182 | 294 | 234 | 328 | 303 | 210 | 241 | 76 | 87 | 94 | 197 | 238 | 717 | 384 | 303 | 120 | 184 | 276 | 82 | 204 | 140 |
| Endoplasmic Reticulum | 0 | 3 | 9 | 0 | 11 | 9 | 55 | 69 | 22 | 50 | 15 | 6 | 1 | 4 | 11 | 45 | 31 | 21 | 0 | 2 | 16 | 3 | 9 | 10 |
| Endosome | 0 | 0 | 0 | 0 | 0 | 0 | 0 | 1 | 0 | 0 | 0 | 0 | 0 | 0 | 0 | 0 | 0 | 0 | 0 | 0 | 0 | 0 | 0 | 0 |
| Golgi | 0 | 0 | 1 | 1 | 0 | 0 | 3 | 7 | 6 | 7 | 3 | 2 | 0 | 0 | 0 | 3 | 1 | 0 | 0 | 0 | 0 | 0 | 1 | 0 |
| Mitochondria | 0 | 0 | 0 | 0 | 0 | 0 | 2 | 3 | 13 | 19 | 5 | 8 | 0 | 0 | 0 | 5 | 1 | 0 | 0 | 0 | 1 | 0 | 1 | 1 |
| Nucleus | 0 | 0 | 0 | 0 | 0 | 0 | 1 | 1 | 0 | 0 | 0 | 0 | 0 | 0 | 0 | 0 | 0 | 0 | 0 | 1 | 0 | 0 | 0 | 0 |
| Nuclear Periphery | 0 | 0 | 0 | 0 | 1 | 0 | 0 | 0 | 1 | 0 | 0 | 0 | 0 | 0 | 0 | 0 | 0 | 0 | 0 | 0 | 0 | 0 | 0 | 0 |
| Nucleolus | 0 | 0 | 0 | 0 | 0 | 0 | 0 | 0 | 0 | 0 | 1 | 1 | 0 | 0 | 0 | 0 | 0 | 0 | 0 | 0 | 0 | 0 | 0 | 0 |
| Peroxisomes | 0 | 0 | 0 | 0 | 0 | 0 | 0 | 0 | 0 | 0 | 0 | 0 | 0 | 0 | 0 | 0 | 0 | 0 | 0 | 0 | 0 | 0 | 0 | 0 |
| SpindlePole | 0 | 0 | 0 | 0 | 0 | 0 | 0 | 0 | 0 | 0 | 0 | 0 | 0 | 0 | 0 | 0 | 0 | 0 | 0 | 0 | 0 | 0 | 0 | 0 |
| Vac/Vac Membrane | 0 | 0 | 0 | 1 | 3 | 0 | 1 | 6 | 2 | 0 | 2 | 2 | 0 | 0 | 0 | 2 | 1 | 0 | 0 | 1 | 1 | 0 | 0 | 2 |
| Unique Cell Count | 128 | 196 | 308 | 184 | 309 | 246 | 402 | 395 | 258 | 323 | 102 | 115 | 95 | 200 | 248 | 728 | 388 | 306 | 122 | 195 | 302 | 89 | 220 | 158 |
| Labelled Cell Count | 128 | 196 | 311 | 186 | 314 | 249 | 421 | 409 | 280 | 352 | 111 | 126 | 95 | 202 | 251 | 776 | 424 | 327 | 122 | 195 | 302 | 89 | 220 | 158 |
Yeast GFP Assignment
Protein Abundance
| Screen | WT1 | WT2 | WT3 | RAP60 | RAP140 | RAP220 | RAP300 | RAP380 | RAP460 | RAP540 | RAP620 | RAP700 | HU80 | HU120 | HU160 | rpd3Δ_1 | rpd3Δ_2 | rpd3Δ_3 | AF100 | AF140 | AF180 |
|---|---|---|---|---|---|---|---|---|---|---|---|---|---|---|---|---|---|---|---|---|---|
| Mean Cell GFP Intensity (1e-4) | 89.2 | 101.5 | 86.0 | 85.3 | 72.5 | 64.2 | 51.4 | 43.8 | 41.6 | 38.4 | 33.8 | 36.7 | 91.1 | 88.6 | 86.2 | 115.0 | 133.8 | 142.1 | 80.3 | 84.3 | 86.6 |
| Std Deviation (1e-4) | 19.5 | 24.0 | 20.6 | 23.6 | 20.5 | 15.9 | 13.2 | 12.9 | 13.5 | 11.9 | 10.8 | 13.4 | 16.6 | 18.5 | 17.1 | 28.6 | 35.8 | 41.1 | 23.6 | 17.7 | 19.1 |
| Intensity Change (Log2) | – | – | – | -0.01 | -0.25 | -0.42 | -0.74 | -0.97 | -1.05 | -1.16 | -1.35 | -1.23 | 0.08 | 0.04 | 0.0 | 0.42 | 0.64 | 0.73 | -0.1 | -0.03 | 0.01 |
Localization Change
| Localization | RAP60 | RAP140 | RAP220 | RAP300 | RAP380 | RAP460 | RAP540 | RAP620 | RAP700 | HU80 | HU120 | HU160 | rpd3Δ_1 | rpd3Δ_2 | rpd3Δ_3 |
|---|---|---|---|---|---|---|---|---|---|---|---|---|---|---|---|
| Cortical Patches | 0 | 0 | 0 | 0 | 0 | 3.8 | 4.0 | 0 | 0 | 0 | 0 | 0 | 0 | 0 | 0 |
| Bud | 0 | 0 | 0 | 0 | 0 | 0 | 0 | 0 | 0 | 0 | 0 | 0 | 0 | 0 | 0 |
| Bud Neck | 0 | 0 | 0 | 0 | 0 | 0 | 0 | 0 | 0 | 0 | 0 | 0 | 0 | 0 | 0 |
| Bud Site | 0 | 0 | 0 | 0 | 0 | 0 | 0 | 0 | 0 | 0 | 0 | 0 | 0 | 0 | 0 |
| Cell Periphery | 0 | 0 | 0 | 3.3 | 1.9 | 3.1 | 3.7 | 0 | 0 | 0 | 0 | 0 | 0 | 0 | 0 |
| Cytoplasm | 1.3 | -1.2 | -1.2 | -6.4 | -7.6 | -6.2 | -8.0 | -7.1 | -6.9 | 1.0 | 1.0 | -0.7 | 1.5 | 1.8 | 1.7 |
| Endoplasmic Reticulum | 0 | 0.4 | 0.5 | 5.0 | 6.1 | 2.9 | 5.4 | 4.4 | 0 | 0 | -0.6 | 1.0 | 2.2 | 2.9 | 2.3 |
| Endosome | 0 | 0 | 0 | 0 | 0 | 0 | 0 | 0 | 0 | 0 | 0 | 0 | 0 | 0 | 0 |
| Golgi | 0 | 0 | 0 | 0 | 0 | 0 | 0 | 0 | 0 | 0 | 0 | 0 | 0 | 0 | 0 |
| Mitochondria | 0 | 0 | 0 | 0 | 0 | 4.0 | 4.3 | 0 | 0 | 0 | 0 | 0 | 0 | 0 | 0 |
| Nucleus | 0 | 0 | 0 | 0 | 0 | 0 | 0 | 0 | 0 | 0 | 0 | 0 | 0 | 0 | 0 |
| Nuclear Periphery | 0 | 0 | 0 | 0 | 0 | 0 | 0 | 0 | 0 | 0 | 0 | 0 | 0 | 0 | 0 |
| Nucleolus | 0 | 0 | 0 | 0 | 0 | 0 | 0 | 0 | 0 | 0 | 0 | 0 | 0 | 0 | 0 |
| Peroxisomes | 0 | 0 | 0 | 0 | 0 | 0 | 0 | 0 | 0 | 0 | 0 | 0 | 0 | 0 | 0 |
| SpindlePole | 0 | 0 | 0 | 0 | 0 | 0 | 0 | 0 | 0 | 0 | 0 | 0 | 0 | 0 | 0 |
| Vacuole | 0 | 0 | 0 | 0 | 0 | 0 | 0 | 0 | 0 | 0 | 0 | 0 | 0 | 0 | 0 |
External localization resources
Images






























Protein Concentration and Protein Localization Data
| R1 | R2 | R3 | ||||||||||||||||
|---|---|---|---|---|---|---|---|---|---|---|---|---|---|---|---|---|---|---|
| G1 Pre-START | G1 Post-START | S/G2 | Metaphase | Anaphase | Telophase | G1 Pre-START | G1 Post-START | S/G2 | Metaphase | Anaphase | Telophase | G1 Pre-START | G1 Post-START | S/G2 | Metaphase | Anaphase | Telophase | |
| Concentration | 85.059 | 117.4392 | 104.1007 | 104.882 | 89.5673 | 115.8765 | 84.2606 | 122.0421 | 107.0797 | 94.5135 | 107.7273 | 114.6937 | 90.1508 | 127.4035 | 109.1946 | 113.357 | 87.742 | 110.7711 |
| Actin | 0.0028 | 0.0006 | 0.0024 | 0.0001 | 0.0026 | 0.0005 | 0.0141 | 0.0005 | 0.0083 | 0.014 | 0.0002 | 0.0048 | 0.0119 | 0.0003 | 0.002 | 0.0001 | 0.0347 | 0.0028 |
| Bud | 0.0024 | 0.0009 | 0.0017 | 0.0016 | 0.0011 | 0.0009 | 0.0022 | 0.0006 | 0.0017 | 0.0025 | 0.0005 | 0.0073 | 0.0015 | 0.0003 | 0.0013 | 0.0015 | 0.0016 | 0.0024 |
| Bud Neck | 0.001 | 0.0009 | 0.0011 | 0.0011 | 0.0009 | 0.0017 | 0.0009 | 0.0003 | 0.0005 | 0.0011 | 0.0006 | 0.0025 | 0.0007 | 0.0003 | 0.0006 | 0.0006 | 0.0006 | 0.0018 |
| Bud Periphery | 0.0041 | 0.0011 | 0.0019 | 0.0016 | 0.0005 | 0.0006 | 0.003 | 0.0003 | 0.0012 | 0.0034 | 0.0001 | 0.0051 | 0.0018 | 0.0001 | 0.0012 | 0.0007 | 0.0025 | 0.0019 |
| Bud Site | 0.0012 | 0.0008 | 0.0007 | 0.0003 | 0.0002 | 0.0002 | 0.0032 | 0.0011 | 0.0035 | 0.0004 | 0 | 0.0029 | 0.0017 | 0.0003 | 0.0007 | 0.0003 | 0.0014 | 0.0022 |
| Cell Periphery | 0.0312 | 0.018 | 0.0239 | 0.0305 | 0.0032 | 0.0035 | 0.0087 | 0.0036 | 0.0091 | 0.0062 | 0.0005 | 0.003 | 0.0127 | 0.0124 | 0.0102 | 0.0164 | 0.0031 | 0.0303 |
| Cytoplasm | 0.5924 | 0.8324 | 0.6933 | 0.4857 | 0.7095 | 0.8081 | 0.8388 | 0.9573 | 0.9024 | 0.7594 | 0.9644 | 0.7686 | 0.7421 | 0.9558 | 0.8429 | 0.7721 | 0.6614 | 0.8158 |
| Cytoplasmic Foci | 0.0041 | 0.0007 | 0.0018 | 0.001 | 0.0046 | 0.0026 | 0.0099 | 0.0041 | 0.0023 | 0.0019 | 0.002 | 0.0128 | 0.0142 | 0.0006 | 0.0115 | 0.0029 | 0.0212 | 0.0161 |
| Eisosomes | 0.0002 | 0.0005 | 0.0004 | 0 | 0.0001 | 0 | 0.0018 | 0 | 0 | 0.0002 | 0 | 0 | 0.0004 | 0 | 0.0002 | 0 | 0.0004 | 0.0006 |
| Endoplasmic Reticulum | 0.0493 | 0.0267 | 0.017 | 0.0177 | 0.0082 | 0.0089 | 0.0283 | 0.0062 | 0.0047 | 0.0085 | 0.0037 | 0.0188 | 0.0374 | 0.0024 | 0.0101 | 0.0018 | 0.0085 | 0.0231 |
| Endosome | 0.0083 | 0.0018 | 0.005 | 0.0055 | 0.0111 | 0.0284 | 0.0073 | 0.0009 | 0.008 | 0.0134 | 0.0036 | 0.0312 | 0.0108 | 0.0007 | 0.0077 | 0.0083 | 0.0105 | 0.0063 |
| Golgi | 0.0015 | 0.0006 | 0.0008 | 0.0001 | 0.0043 | 0.0026 | 0.0032 | 0.0004 | 0.0007 | 0.0051 | 0.0001 | 0.0086 | 0.0044 | 0.0001 | 0.0055 | 0.0003 | 0.0056 | 0.0017 |
| Lipid Particles | 0.0044 | 0.0011 | 0.0017 | 0.0005 | 0.0342 | 0.0006 | 0.0039 | 0.0008 | 0.0005 | 0.0008 | 0.0002 | 0.0018 | 0.01 | 0.0006 | 0.0041 | 0.0018 | 0.0083 | 0.0062 |
| Mitochondria | 0.0094 | 0.0007 | 0.0068 | 0.0004 | 0.009 | 0.0023 | 0.0101 | 0.0015 | 0.0006 | 0.0608 | 0.0001 | 0.0609 | 0.0143 | 0.0001 | 0.0075 | 0.0005 | 0.0641 | 0.0032 |
| None | 0.0028 | 0.0002 | 0.0006 | 0.0002 | 0.0008 | 0.0003 | 0.006 | 0.0003 | 0.0035 | 0.0006 | 0.0003 | 0.0016 | 0.0046 | 0.0001 | 0.0043 | 0.0004 | 0.0138 | 0.0102 |
| Nuclear Periphery | 0.0443 | 0.0085 | 0.0112 | 0.0169 | 0.0272 | 0.0109 | 0.0091 | 0.0009 | 0.0047 | 0.0092 | 0.0051 | 0.0026 | 0.0203 | 0.0024 | 0.0064 | 0.0038 | 0.0074 | 0.0037 |
| Nucleolus | 0.0018 | 0.0003 | 0.0009 | 0.0007 | 0.0007 | 0.0002 | 0.0008 | 0.0002 | 0.0002 | 0.0002 | 0 | 0.0014 | 0.0018 | 0.0001 | 0.0007 | 0.0006 | 0.0022 | 0.0073 |
| Nucleus | 0.012 | 0.0027 | 0.005 | 0.0065 | 0.004 | 0.0041 | 0.005 | 0.0009 | 0.0027 | 0.0035 | 0.0026 | 0.0055 | 0.0054 | 0.0011 | 0.0026 | 0.0037 | 0.0039 | 0.0078 |
| Peroxisomes | 0.0017 | 0 | 0.0035 | 0 | 0.0099 | 0.0001 | 0.0005 | 0.0003 | 0.0001 | 0.0001 | 0 | 0.0008 | 0.0025 | 0 | 0.0008 | 0.0001 | 0.0049 | 0.0004 |
| Punctate Nuclear | 0.0088 | 0 | 0.0001 | 0 | 0.0016 | 0.0001 | 0.0011 | 0.0001 | 0.0006 | 0.0001 | 0.0001 | 0.0002 | 0.0013 | 0 | 0.0006 | 0 | 0.0009 | 0.0068 |
| Vacuole | 0.1594 | 0.0866 | 0.178 | 0.3374 | 0.1135 | 0.0759 | 0.0371 | 0.0184 | 0.0396 | 0.0856 | 0.0128 | 0.0444 | 0.0814 | 0.021 | 0.0682 | 0.1577 | 0.077 | 0.0414 |
| Vacuole Periphery | 0.057 | 0.015 | 0.0421 | 0.092 | 0.0527 | 0.0476 | 0.0049 | 0.0012 | 0.0051 | 0.023 | 0.0028 | 0.015 | 0.019 | 0.0013 | 0.011 | 0.0264 | 0.0662 | 0.0079 |
Sequencing Data
| R1 | R2 | |||||||||
|---|---|---|---|---|---|---|---|---|---|---|
| G1 Post-START | S/G2 | Metaphase | Anaphase | Telophase | G1 Post-START | S/G2 | Metaphase | Anaphase | Telophase | |
| Gene Expression | 91.9504 | 71.6119 | 70.6981 | 108.3308 | 104.3155 | 93.9881 | 92.0825 | 104.5386 | 91.6126 | 108.77 |
| Translational Efficiency | 1.3987 | 1.7981 | 1.6568 | 1.1541 | 1.316 | 1.3581 | 1.4304 | 1.161 | 1.3864 | 1.2402 |
Hit Data
| Dataset | Hit |
|---|---|
| Protein Concentration | ✘ |
| Protein Localization | ✘ |
| Gene Expression | ✘ |
| Translational Efficiency | ✘ |
Endocytosis
| Temp | Actin Patch (Sac6-tdTomato) | Cortical Patch (Sla1-GFP) | Late Endosome (Snf7-GFP) | Vacuole (Vph1-GFP) |
|---|---|---|---|---|
| 37℃ | ||||
| RT |
Cell Cycle Omics
CYCLoPs (Hom3-GFP)
| Gene / Allele | Actin Patch (Sac6-tdTomato) | Cortical Patch (Sla1-GFP) | Late Endosome (Snf7-GFP) | Vacuole (Sac6-tdTomato) |
|---|
| Gene | Images |
|---|
| Gene | Images |
|---|
Images are not yet available
Images are not yet available